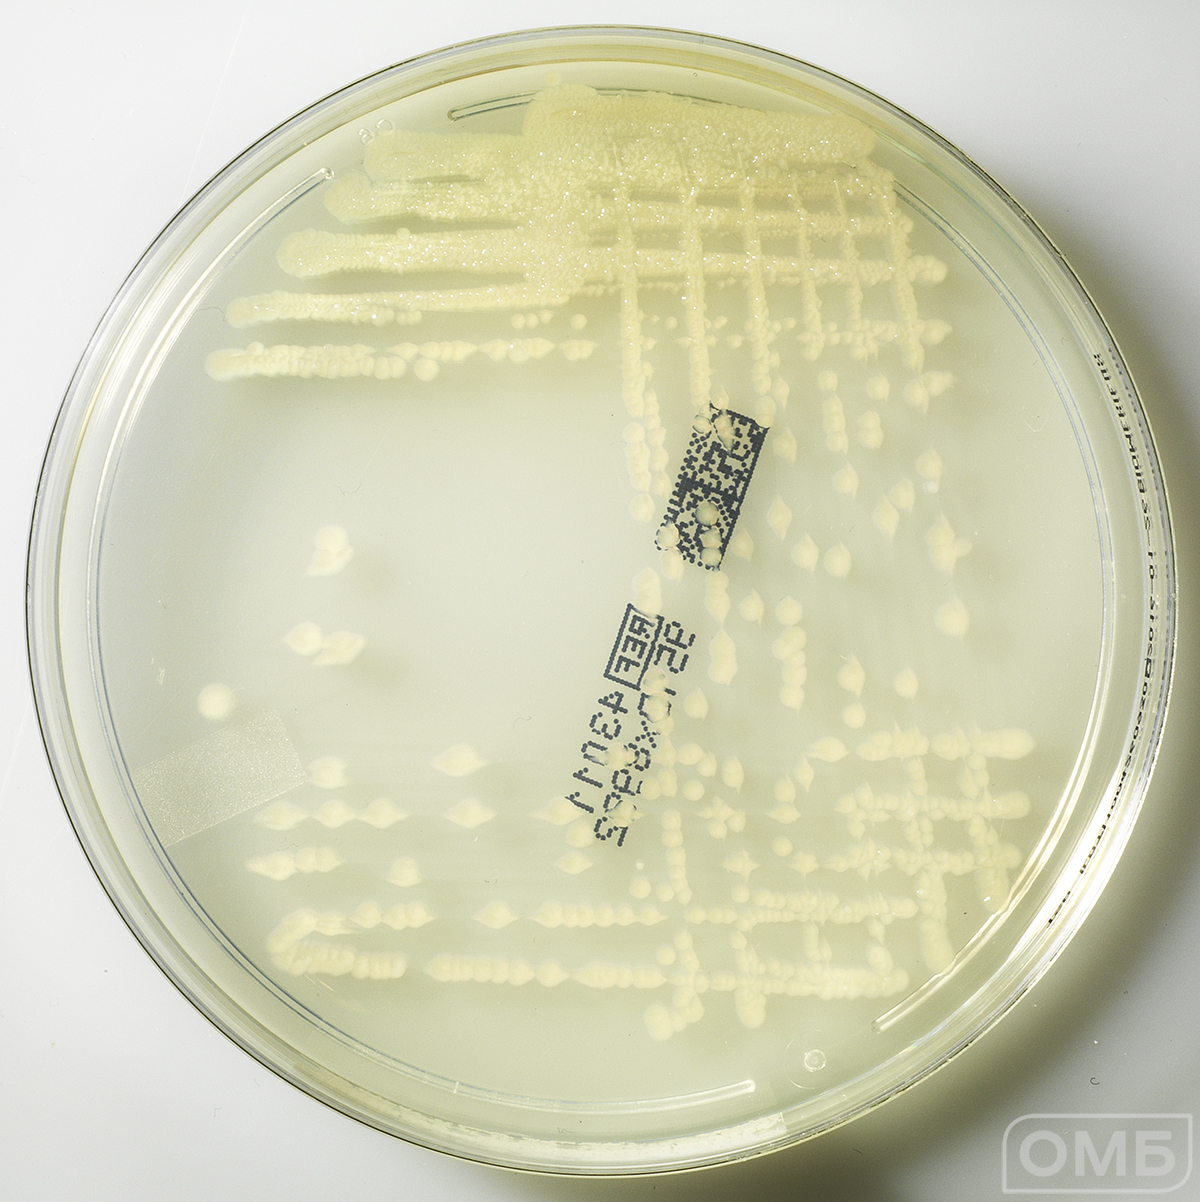
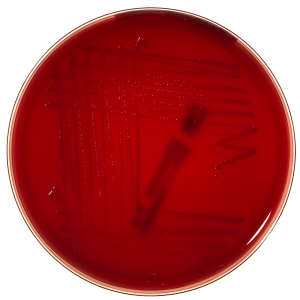
Campylosel Agar - Агар для селективного выделения бактерий рода Campylobacter
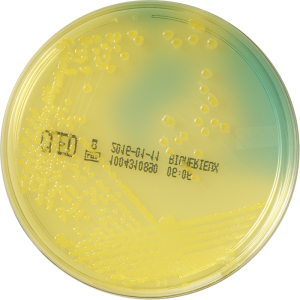
CLED Аgar - Агар для выделения   микроорганизмов из мочевого тракта
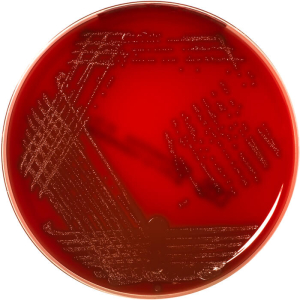
Columbia agar+5% sheep blood - Колумбийский агар + 5 % бараньей крови

Trypcase-Soy Agar - Трипказо-соевый агар 43011
Производитель: bioMerieux SA
Фасовка: 20 шт
Временно не поставляется
Нормативный максимальный срок поставки (календарных дней): 90
Фасовка: 20 шт
Регистрационное удостоверение: ФСЗ 2011/10306
Сертификат/декларация соответствия: Не подлежит обязательной сертификации
Класс опасности: не опасный
Остаточный срок годности, признаваемый годным (дней): 71
Вес (нетто): 0,732 кг.
Объем (нетто): 0,002787 куб.м.
Транспортировка при: +2°С +8°С
Условия хранения: +2°С +8°С
(Инструкция - PDF, 192 KB)

и узнайте цену
Условия покупки
-
 1. Заполните заявку по шаблону
1. Заполните заявку по шаблону -
 2. Отправьте заявку на почту zakaz@omb.ru Мы уточним все детали по заявке и подготовим договор о сотрудничестве и/или счет
2. Отправьте заявку на почту zakaz@omb.ru Мы уточним все детали по заявке и подготовим договор о сотрудничестве и/или счет -
 3. Согласуйте и подпишите договор. Отправьте его ответным письмом
3. Согласуйте и подпишите договор. Отправьте его ответным письмом -
 4. Оплатите счет по вашему заказу После оплаты счета мы приступаем к сборке заказа и готовим его к отправке
4. Оплатите счет по вашему заказу После оплаты счета мы приступаем к сборке заказа и готовим его к отправке -
 5. Примите ваш заказ с доставкой или заберите самовывозом со склада ОМБ
5. Примите ваш заказ с доставкой или заберите самовывозом со склада ОМБ
Более подробную информацию можной найти в разделе Условия покупки
Внимание!
Размещенная на сайте www.omb.ru информация (в том числе рекламного характера), а также графические образы и изображения медицинских изделий представлены исключительно для сотрудников медицинских организаций/медицинских работников - пользователей медицинских изделий и поставщиков медицинских изделий.
Нажимая на кнопку «Продолжить» и оставаясь на указанном сайте, вы подтверждаете, что являетесь медицинским работником, либо поставщиком медицинских изделий и принимаете на себя ответственность за несоблюдение указанного ограничения.